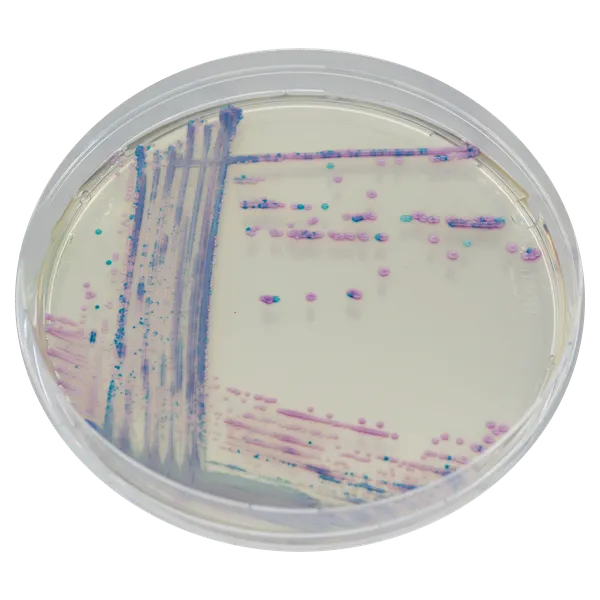
CHROMagar™ Staph aureus

Hình thái khuẩn lạc

S. aureus
màu hồng đến tím nhạt

Vi khuẩn khác
không màu, màu xanh hoặc bị ức chế
Hiệu năng
Hiệu năng
Mục đích sử dụng:
CHROMagar™ Staph aureus là môi trường nuôi cấy chromogen chọn lọc dùng để phát hiện trực tiếp, phân biệt và nhận dạng sơ bộ Staphylococcus aureus nhằm hỗ trợ chẩn đoán tình trạng mang mầm bệnh S. aureus. Xét nghiệm được thực hiện với các mẫu swab từ da, vết thương hoặc mô mềm. Kết quả có thể được đọc sau 18-24 giờ ủ hiếu khí ở 35-37 °C.
Môi trường này cũng có thể được sử dụng như là một chỉ báo cảnh báo sớm cho xét nghiệm chẩn đoán các nhiễm trùng để báo hiệu sự hiện diện có thể của S. aureus. Cách sử dụng này không thay thế các quy trình của cơ sở.
Các môi trường song hành là cần thiết để thu hồi các vi sinh vật để thử nghiệm vi sinh vật chi tiết hoặc phân loại dịch tễ học. Thiếu sự phát triển hoặc thiếu khuẩn lạc trên CHROMagar™ Staph aureus không loại trừ sự hiện diện của S. aureus. CHROMagar™ Staph aureus không được sử dụng để chẩn đoán nhiễm trùng hay hướng dẫn hoặc giám sát điều trị cho nhiễm trùng.
CHROMagar™ Staph aureus cũng có thể được sử dụng trong việc phát hiện S. aureus trong các phân tích sản phẩm thực phẩm cho tiêu dùng của con người, thức ăn chăn nuôi và trong các mẫu môi trường.
Kiểm soát chất lượng thực phẩm & môi trường:
Con người là nguồn dự trữ chính của S. aureus. Người mang mầm bệnh có thể làm ô nhiễm môi trường xung quanh khi ho, hắt hơi và khi chạm vào thực phẩm bằng tay. Nó thường được tìm thấy trong môi trường và trên bề mặt chế biến thực phẩm và cũng trong một số thực phẩm chưa nấu chín (sản phẩm từ sữa, salad, bánh sandwich...). Quan trọng là phải kiểm tra sự hiện diện của S. aureus trước và sau quá trình tiệt trùng thực phẩm.
1. Dễ chuẩn bị: Môi trường thông thường cho S. aureus là Baird-Parker cần phải được bổ sung với RPF (Rabbit Plasma Fibrinogen), làm cho quá trình sản xuất đĩa phức tạp và cũng giảm thời hạn sử dụng của các đĩa đã đổ xuống còn vài tuần.
Ngược lại, CHROMagar™ Staph aureus đi kèm với tất cả các thành phần đã có trong thạch (không cần bổ sung thêm) và giữ được sự ổn định.
2. Nhanh chóng: Kết quả trên Baird Parker cần được đọc sau 48 giờ ủ, trong khi với CHROMagar™ Staph aureus, kết quả sẵn có chỉ sau 24 giờ.
Ứng dụng lâm sàng:
S. aureus là nguyên nhân chính gây nhiễm trùng da và mô mềm và cũng có thể gây nhiễm trùng nghiêm trọng như nhiễm trùng máu, viêm phổi hoặc nhiễm trùng xương và khớp.
1. Dễ đọc: so với thạch máu hay Thạch Mannitol Salt. CHROMagar™ Staph aureus cho phép dễ dàng phân biệt khuẩn lạc S. aureus hơn nhờ màu tím nhạt và giúp nhận dạng khuẩn lạc nghi ngờ dễ dàng hơn, do đó giảm bớt khối lượng công việc xác nhận.
Thành phần

Tài liệu kỹ thuật
Công bố khoa học
2023
CHROMagar Staph aureus for the enumeration at 37°C of Staphylococcus aureus and other coagulase positive staphylococci in human food and animal feed products
📄 Publication2018
Validation and implementation of Colorex™ CHROMagar™ Staph aureus on WASP/WASPLab™ for screening for Staphylococcus aureus using the Eswab™
📄 Publication2018
Multicentre Validation of a Chromogenic Medium for Screening of Staphylococcus aureus in Respiratory Samples from Cystic Fibrosis Patients
📄 Publication2004
Optimal detection of Staphylococcus aureus from clinical specimens using a new chromogenic medium
📄 Publication2003
Use of a new chromogenic culture medium facilitates detection of Staphylococcus aureus in a screening program
📄 Publication2001
Performance of the chromogenic medium CHROMagar Staph aureus and the Staphylochrom coagulase test in the detection and identification of Staphylococcus aureus in clinical specimens
📄 Publication2012
Performance of CHROMagar Staph aureus and CHROMagar MRSA for Detection of Airborne Methicillin-Resistant and Methicillin-Sensitive Staphylococcus aureus DOI: 10.1080/02786826.2011.626001
📄 Publication2011
Evaluation of CHROMagar and Pastorex Test in Identification of Staphylococcus aureus Afaf Abd El Rahman, Abeer El sayed and Afaf Mahmood
📄 Publication2004
Evaluacion del nuevo medio cromogenico “CHROMagar Staph aureus” para identification presuntiva de S.aureus (Poster in spanish)
📄 Publication2003
Evaluation of Chromogenic Medium for the Rapid and Presumptive Identification of Staphylococcus aureus from Food Specimens
📄 Publication2001
Evaluation of CHROMagar Staph aureus, a new chromogenic medium, for isolation and presumptive identification of Staphylococcus aureus from human clinical specimens
📄 Publication2000
Dépistage nasal de Staphylococcus aureus. Nécessité de standardiser les protocoles
📄 Publication

Xem thêm